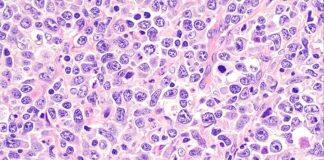
Breakthrough gives hope in fight against aggressive form of blood cancer

About United Kingdom Education News, Study in United Kingdom, Education in United Kingdom, United Kingdom University, University News, University Ranking, Study Abroad, Online Education, Education News, Education Fairs, Job Opportunities, Graduate Program, Undergraduate Programs, Admissions, etc…
Tag: United Kingdom News
University of Birmingham researchers named among most influential in the world
University of Birmingham researchers have been recognised among the world’s most influential academics across a range of fields, according to new rankings.
School pupils lead the green charge at climate action event
More than 100 pupils and teachers from across North East England gathered on campus for a special event to help them take meaningful action on climate change.
Breakthrough gives hope in fight against aggressive form of blood cancer
Researchers at the University of Southampton have identified a new subtype of lymphoma which could pave the way to improved and more targeted treatments for some blood cancer patients.
Engineers tackle disability barriers
A Leeds alum helped bring together the University and a UK charity to create bespoke solutions for disabled people.
Continents peel from below, triggering oceanic volcanoes
Earth scientists have discovered how continents are slowly peeled from beneath, fuelling volcanic activity in an unexpected place: the oceans.
New drug candidate offers hope to slow down MND progress
A groundbreaking drug candidate found to protect nerve cells damaged by motor neuron disease (MND), could offer new hope to people living with the devastating condition.
Purple plaque for trailblazing entrepreneur
A purple plaque has been unveiled at the University of Leeds for the first time after a researcher won a prestigious UK Women in Innovation award.
Children’s dental health still very poor despite interventions
Improving children's access to NHS dentists and reducing rates of tooth decay should remain a top national government priority, oral health experts say.
Children’s dental health still very poor despite interventions
Children's access to NHS dentists and rates of tooth decay remain very poor despite improvements from national Government interventions, oral health experts say.
Engineering firm which saved ancient warship and solves air crash mysteries...
Scientists behind an engineering consultancy in Southampton which helped save an ancient warship have celebrated their successes after reaching a 10-year milestone.